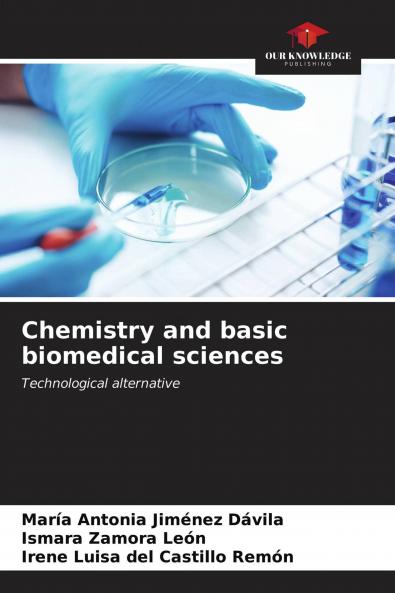
Chemistry and basic biomedical sciences

English
Paperback
₹3540
(All inclusive*)
Delivery Options
Please enter pincode to check delivery time.
*COD & Shipping Charges may apply on certain items.
Review final details at checkout.
Looking to place a bulk order? SUBMIT DETAILS
About The Book
Description
Author
The teaching-learning process of Chemistry requires constant updating in correspondence with the demands of the training of health professionals. The elaboration of an educational software to support teaching for the linking of Chemistry with Basic Biomedical Sciences is implemented as a technological alternative in the careers of Health Technology at the University of Medical Sciences of Granma Cuba. A quasi-experiment was applied with an exit test for the experimental group and the results showed a qualitative leap in the students'' learning since most of them were able to establish the relationship between molecular cause-disease-practical application of chemical contents. The implementation in the educational practice of the technological alternative allowed to raise the level of learning of the chemical contents in their practical applications in the field of health.
Delivery Options
Please enter pincode to check delivery time.
*COD & Shipping Charges may apply on certain items.
Review final details at checkout.
Details
ISBN 13
9786203662740
Publication Date
-26-04-2021
Pages
-64
Weight
-101 grams
Dimensions
-150x220x3.89 mm